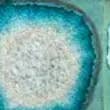

Similar products
Similar products

Bestseller
Wholesale Geode Crackle Coaster - Individual - 4" x 4" - Fused Glass
WSP
$12.00 MSRP
Shipping & policies
- Estimated delivery Apr 7-May 4
Free and easy returns. Learn more
With Faire, shop unique wholesale products for your store from brands like Dock 6 Pottery and more.
Description
Our classic square coasters are approx 4" x 4" and $5.50 ea These coasters do not contain actual geodes, but are reminiscent of the beautiful crystals. Choose from several glaze colors to suit any home decor style. Orders of 4 of the same color will be sent in arrangements that compliment each other as sets. Each coaster is one of a kind and unique, but we will happily group similar coasters together so they can be sold as matching sets of 4. Square Coasters, Pottery, and Specialty Shapes have different lead times. If your order contains a combination of these products they will be shipped together when the order is fully complete. If you would like your items to be shipped separately based on their different lead times, we suggest placing separate orders for Square Coasters, Pottery, and Specialty Shapes. Handmade ceramic coaster, coaster set, geode coaster, celestial coaster, agate coaster, dock 6 coaster
Details
Made in United States Weight: 425.24 g (15 oz) Dimensions: 10.2 x 10.2 x 1.3 cm (4 x 4 x 0.5 in)
Ratings and reviews
Relevance
Top Shop celebrates exceptional brands who have earned a 4.8+ rating over the last 12 months, fulfill orders quickly and smoothly, and maintain a fresh catalog.
4.9
Brand rating ()
5
5
178
178
4
4
6
6
3
3
2
2
2
2
1
1
1
1
0
0
5.0
Quality of products
5.0
Fulfillment
5.0
Communication

Geode Crackle Coaster - Individual - 4" x 4" - Fused Glass
Just beutiful.
Just beutiful.
18. März 2025 • agostino • Orleans, MA, United States

Geode Crackle Coaster - Individual - 4" x 4" - Fused Glass
Beautiful products - our customers love them.
Beautiful products - our customers love them.
29. Okt. 2024 • Amanda • Manawa, WI, United States

Geode Crackle Coaster - Individual - 4" x 4" - Fused Glass
Really neat coasters that our customers love! We are repeat customers and always pleased. Thanks!
Really neat coasters that our customers love! We are repeat customers and always pleased. Thanks!
7. Nov. 2023 • Michael • Cambria, CA, United States

Geode Crackle Coaster - Individual - 4" x 4" - Fused Glass
Beautiful products and realistic and transparent shipping times!!
Beautiful products and realistic and transparent shipping times!!
10. Jan. 2023 • Susan • Saint Charles, MO, United States

Geode Crackle Coaster - Individual - 4" x 4" - Fused Glass
Beautiful
Beautiful
26. Okt. 2021 • Kathy • Manistique, MI, United States